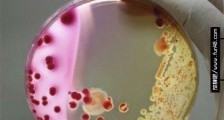

-
- 最早的塑料制品 1860年发明的硝酸纤维塑料
- 最早的塑料制品是什么样子?塑料是以单体为原料,通过加聚或缩聚反应聚合而成的高分子化合物(macromolecules),其抗形变能力中等,介于纤维和橡胶之间,由合成树脂及填料、增塑剂、稳...
-
- 四川省印发公共机构“禁塑令” 禁塑目录时间表公布
- 11月25日,记者从四川省机关事务管理局获悉,该局已印发《关于全省公共机构禁止使用不可降解一次性塑料制品工作的通知》,明确提出塑料污染治理的工作要求。 《通知》按照...
-
- 多地出台塑料污染治理政策措施——新“限塑令”新在哪
- 今年,我国率先在部分地区、部分领域禁止、限制部分塑料制品的生产、销售和使用。当前,各地正在着力推进新版“限塑令”的落地实施。5uC豪仕阅读网https://www.Haoz.net
...
-
- 由“限”改“禁” 海南全面“禁塑”进入倒计时
- 由“限”改“禁”,分种类逐步替代一次性塑料制品fKf豪仕阅读网
海南全面“禁塑”倒计时fKf豪仕阅读网
海面上漂浮的垃圾八成是塑料,严重威胁海洋生态,成为海南绿色...
-
- 酒店一次性塑料用品等拟被禁止使用 具体有哪些要求?
- 4月10日,国家发改委发布关于《禁止、限制生产、销售和使用的塑料制品目录(征求意见稿)》,向社会公开征求意见。意见稿提出,以医疗废物为原料制造的塑料制品、含塑料微珠的日化...
-
- 海南出台禁止一次性不可降解塑料制品规定
-
新华社海口2月10日电(记者陈凯姿)海南省生态环境厅10日发布《海南经济特区禁止一次性不可降解塑料制品...
下载TXT电子书,就来曹操读书